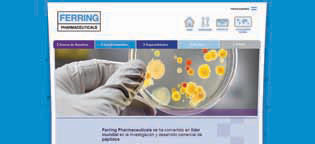

|
Grageas
|
|
|
|

|
|
NEWSLETTER - DICIEMBRE 2012
 Tenemos
el agrado de comunicar que a partir del mes de noviembre de 2012
iniciamos un nuevo proceso de comercialización con la Caja de
Previsión y Seguro Médico de la Provincia de Buenos Aires. La
Caja de Previsión y Seguro Médico de la Provincia de Buenos
Aires administra el sistema de previsión y seguridad social para
los médicos matriculados, respetando los principios de
solidaridad y equidad y asegurando la persistencia del sistema a
lo largo de las generaciones venideras. Los socios de la Caja de
Médicos contarán con productos creados especialmente para ellos
en sus viajes por la Argentina y el resto del mundo para que
todos puedan sentirse siempre tan protegidos como en casa. Tenemos
el agrado de comunicar que a partir del mes de noviembre de 2012
iniciamos un nuevo proceso de comercialización con la Caja de
Previsión y Seguro Médico de la Provincia de Buenos Aires. La
Caja de Previsión y Seguro Médico de la Provincia de Buenos
Aires administra el sistema de previsión y seguridad social para
los médicos matriculados, respetando los principios de
solidaridad y equidad y asegurando la persistencia del sistema a
lo largo de las generaciones venideras. Los socios de la Caja de
Médicos contarán con productos creados especialmente para ellos
en sus viajes por la Argentina y el resto del mundo para que
todos puedan sentirse siempre tan protegidos como en casa.
 También
nos es grato informar que OSAP, Obra Social Acero Paraná, desde
1 de diciembre de este año ha decidido extender el cuidado de
sus socios a todo el país como también a los países limítrofes.
Estamos orgullosos de ser nosotros quienes nos encarguemos de
tan importante tarea. Bienvenidos OSAP y sus 22 mil
beneficiarios al mundo Assist-Card. También
nos es grato informar que OSAP, Obra Social Acero Paraná, desde
1 de diciembre de este año ha decidido extender el cuidado de
sus socios a todo el país como también a los países limítrofes.
Estamos orgullosos de ser nosotros quienes nos encarguemos de
tan importante tarea. Bienvenidos OSAP y sus 22 mil
beneficiarios al mundo Assist-Card.
 ConSalud es la Empresa de Medicina Privada más elegida de la
provincia de Misiones con más de 54 mil afiliados a su cargo.
Prestadores Sanatoriales brinda a sus afiliados un respaldo
serio, sólido, eficaz y confiable, no limitándose solamente a la
cobertura sino a lograr el completo bienestar de sus afiliados.
En Assist-Card sabemos lo que esto significa por lo que será un
gran honor trabajar juntos cuidando y brindando lo mejor de
nosotros a nuestra gente en la Argentina y el resto del mundo. ConSalud es la Empresa de Medicina Privada más elegida de la
provincia de Misiones con más de 54 mil afiliados a su cargo.
Prestadores Sanatoriales brinda a sus afiliados un respaldo
serio, sólido, eficaz y confiable, no limitándose solamente a la
cobertura sino a lograr el completo bienestar de sus afiliados.
En Assist-Card sabemos lo que esto significa por lo que será un
gran honor trabajar juntos cuidando y brindando lo mejor de
nosotros a nuestra gente en la Argentina y el resto del mundo. |
|
|
División Salud de Assist-Card argentina se
renueva
 La
Gerencia Comercial de Assist-Card de Argentina, División Salud,
ha designado a partir del mes de octubre, al Sr. Ariel Pierini
como Jefe de División Salud Argentina, para continuar el
crecimiento sostenido y el desarrollo del área. La
Gerencia Comercial de Assist-Card de Argentina, División Salud,
ha designado a partir del mes de octubre, al Sr. Ariel Pierini
como Jefe de División Salud Argentina, para continuar el
crecimiento sostenido y el desarrollo del área.
Pierini, incursionó en el 2007 en Assist-Card como coordinador
de operaciones, en el Departamento de Asistencias. En el año
2010, fue designado Ejecutivo de Grandes Cuentas, desde allí
mantiene un crecimiento profesional y sólido. Reportará al
Gerente Regional de División Salud LATAM, Daniel R. J.
Piscicelli. Le deseamos el mayor de los éxitos y descartamos que
su conocimiento de la Compañía y su gestión Comercial, le serán
de gran aporte para este nuevo desafío. |
|
|
INTELEXIS MUJER GANADOR DEL
PREMIO MARTIN FIERRO
 DR. ERNESTO VAN DER KOOY / DR.
HECTOR PEZZELLA DR. ERNESTO VAN DER KOOY / DR.
HECTOR PEZZELLA
El programa conducido por el Dr. Guillermo Capuya y Natalia
Marquiegui fue galardonado con el premio Martin Fierro de cable
en el rubro Temas Médicos.
DR. ERNESTO VAN DER KOOY / DR.
HECTOR PEZZELLA |
|
|
SWISS MEDICAL MEDICINA PRIVADA:
NUEVA SUCURSAL EN SANTIAGO DEL ESTERO
 Con
el objetivo de estar más cerca de sus asociados y brindar cada
día un mejor servicio, Swiss Medical Medicina Privada inauguró
una nueva sucursal en Santiago del Estero, Capital. La sede se
encuentra ubicada en Av. Roca (sur) Nº 837 y su horario de
atención es de lunes a viernes de 9 a 18 h. Esta reciente
inversión está pensada para brindar atención personalizada a sus
asociados y prestadores, además de asesoramiento y venta de
todos los productos de Swiss Medical Medicina Privada. Al
presente, la compañía cuenta con más de 55 oficinas de atención
con presencia en todo el país y continúa trabajando para
incrementar la calidad del servicio de salud que presta a más de
770.000 asociados. Con
el objetivo de estar más cerca de sus asociados y brindar cada
día un mejor servicio, Swiss Medical Medicina Privada inauguró
una nueva sucursal en Santiago del Estero, Capital. La sede se
encuentra ubicada en Av. Roca (sur) Nº 837 y su horario de
atención es de lunes a viernes de 9 a 18 h. Esta reciente
inversión está pensada para brindar atención personalizada a sus
asociados y prestadores, además de asesoramiento y venta de
todos los productos de Swiss Medical Medicina Privada. Al
presente, la compañía cuenta con más de 55 oficinas de atención
con presencia en todo el país y continúa trabajando para
incrementar la calidad del servicio de salud que presta a más de
770.000 asociados.
Swiss Medical Group es uno de los principales grupos de la
Argentina, se dedica a la protección de personas y es líder en
el mercado de la salud. Cuenta con más de 8.000 empleados. Las
compañías que lo integran son: Swiss Medical Medicina Privada,
Clínica y Maternidad Suizo Argentina, Sanatorio de los Arcos,
Sanatorio Agote, Clínica Olivos, Clínica San Lucas (Neuquén), 5
Centros Médicos Ambulatorios (Swiss Medical Center Microcentro,
Swiss Medical Center Pueyrredón, Swiss Medical Center Barrio
Norte, Centro Médico San Luis y Swiss Medical Center Olivos), 2
Centros Médicos Ambulatorios de ART (Centro Médico Pringles y
Centro Médico Berazategui), 7 Clínicas Odontológicas (5 en
Buenos Aires, 1 en Neuquén y 1 en Salta), 2 Vacunatorios, SMG
Seguros, SMG LIFE, Instituto de Salta, SMG ART, SMG RE, Ecco
Emergencias Médicas (compañía líder en servicios de atención de
emergencias y urgencias médicas) y Blue Cross & Blue Shield de
Uruguay.
Acerca de Swiss Medical Medicina Privada
Swiss Medical es la compañía de medicina privada de Swiss
Medical Group. Fundada en 1994, brinda cobertura a más de
770.000 asociados en todo el país. Cuenta con una red de más de
60.000 profesionales de todas las especialidades, más de 15.000
prestadores de diagnóstico y tratamiento y más de 10.600
farmacias a nivel nacional. Swiss Medical posee una moderna
concepción en protección médica que responde a los nuevos
desafíos y necesidades planteados por un sistema basado en la
excelencia y la calidad de servicio. |
|
|
LABORATORIOS FERRING PRESENTO SU
NUEVA PAGINA WEB “LAS PERSONAS ESTAN PRIMERO”
CLaboratorios Ferring presentó su página
web con un nuevo diseño que toma como eje un concepto actual:
“las personas están primero”. La nueva página inspira movimiento
y dinamismo, acompañando la realidad de hoy, en la que es
necesario adaptarse a las nuevas necesidades de las personas.
www.ferring.com.ar cuenta con imágenes y contenidos para cada
una de las audiencias con las que interactúa el laboratorio:
público en general; pacientes, que podrán encontrar información
específica sobre las patologías en las que Ferring investiga y
desarrolla medicamentos; y un sector dedicado exclusivamente a
los médicos.
“Para Laboratorios Ferring, cada persona es única, por ello
ajustamos nuestros contenidos a las necesidades e intereses de
quienes se nos acercan”, comento Guillermo Ussher, Gerente
General de Ferring Argentina. “Para Laboratorios Ferring, cada persona es única, por ello
ajustamos nuestros contenidos a las necesidades e intereses de
quienes se nos acercan”, comento Guillermo Ussher, Gerente
General de Ferring Argentina.
Con
actualizaciones permanentes, la nueva página es una genuina
herramienta de interacción y comunicación. |
|
|
UNIVERSAL ASSISTANCE PRESENTO LA
CRUZADA SOLIDARIA “HACETE ECO” A BENEFICIO DEL HOSPITAL DE NIÑOS
DR. PEDRO DE ELIZALDE (EX CASA CUNA)
 Durante
los meses de noviembre, diciembre y enero de 2013, Universal
Assistance, a través de la Fundación Universal Assistance, lleva
a cabo la cruzada solidaria “Hacete Eco”. La misma consiste en
la donación de $ 5 por cada venta de los productos de la empresa
con el objetivo de realizar la compra de un Ecógrafo Doppler
Color a total beneficio del Hospital General de Niños Dr. Pedro
de Elizalde (ex Casa Cuna). Durante
los meses de noviembre, diciembre y enero de 2013, Universal
Assistance, a través de la Fundación Universal Assistance, lleva
a cabo la cruzada solidaria “Hacete Eco”. La misma consiste en
la donación de $ 5 por cada venta de los productos de la empresa
con el objetivo de realizar la compra de un Ecógrafo Doppler
Color a total beneficio del Hospital General de Niños Dr. Pedro
de Elizalde (ex Casa Cuna).
De esta manera, la compañía se suma al plan de trabajo
desarrollado por su Fundación. Esta acción viene a complementar
la labor realizada a lo largo de este año por la Fundación con
el mismo objetivo: ayudar a los médicos del Hospital y a los
pequeños pacientes.
Acerca del Ecógrafo Doppler
El uso del ecógrafo Ecodoppler color mejora el diagnóstico de la
patología pediátrica, ofreciendo al paciente la posibilidad de
no ser invadido con otros métodos de imágenes más ágresivos,
este equipo cuenta con una mayor resolución pudiendo detectar
lesiones más pequeñas en forma más rápida en neonatos y en
lactantes y será destinado a la atención de niños internados en
las Unidades de terapia Intensiva, Terapia Neonatal,
Recuperación Cardiovascular y en Quirófano.
Acerca de la Fundación Universal Assistance
La Fundación UA para el Cuidado de la Salud se creó el 19 de
noviembre de 2010. Sus fundadores, Inés y Oscar Civile, la
gestaron como una propuesta de intervención para disminuir la
desigualdad en salud en la niñez. Está compuesta por un equipo
de profesionales de distintas disciplinas que se agruparon para
un mismo fin: promover la igualdad del derecho a la salud de
niños, niñas y adolescentes menores de 18 años en nuestra
comunidad. Cuenta con el aval de Universal Assistance S.A., una
empresa nacional prestadora de servicios de salud con cobertura
internacional, que hace más de 30 años ofrece asistencia
integral en más de 150 países; comprometida desde el inicio de
sus actividades con el bien común.
|
|
|
LOS PRODUCTORES ASESORES DE
SEGUROS HAN FESTEJADO SU DIA EN EL CENTRO DE ATENCION DE TPC
COMPAÑIA DE SEGUROS
 El
viernes 28 de setiembre, Día Internacional del Productor Asesor
de Seguros, TPC los invitó a disfrutar de un servicio de
cafetería en su Centro de Atención como también a participar en
juegos y sorteos desde su Facebook / TPC Compañía de Seguros,
con el objetivo de agasajarlos y comunicarles también las
novedades comerciales de la Compañía. Productoras del interior y
de la Ciudad de Buenos Aires han sido ganadoras en divertidos
juegos que la Compañía organizó en su fanpage. El
viernes 28 de setiembre, Día Internacional del Productor Asesor
de Seguros, TPC los invitó a disfrutar de un servicio de
cafetería en su Centro de Atención como también a participar en
juegos y sorteos desde su Facebook / TPC Compañía de Seguros,
con el objetivo de agasajarlos y comunicarles también las
novedades comerciales de la Compañía. Productoras del interior y
de la Ciudad de Buenos Aires han sido ganadoras en divertidos
juegos que la Compañía organizó en su fanpage.
TPC desea transmitirle a toda la red de Productores su
agradecimiento por el trabajo que llevan adelante al potenciar
la conciencia aseguradora en nuestra sociedad, como también en
el importantísimo aporte que realizan para que las Compañías se
adapten a las necesidades del mercado. ¡Felicitaciones a las
ganadoras! n1ER. MARATON SOLIDARIA ADMIFARM GROUP.
|
|
|
 ¡LLEGAMOS
! ¡LLEGAMOS
!
SÓLO TENEMOS PALABRAS DE AGRADECIMIENTO
El pasado 4 de noviembre se llevó a cabo
nuestra 1er Maratón Solidaria y fue una jornada muy especial. La
convocatoria sumó a más de 1300 personas. Nos acompañaron muchas
Empresas.
Asistieron amigos y familias enteras, participaron grandes y
chicos, todos unidos con un mismo fin: colaborar con la
Asociación Síndrome de Down de la Republica Argentina, la
Fundación Pequeños Gestos Grandes Logros y la Obra del Padre
Mario Pantaleo.
Estos fueron los primeros “Kilómetros de Solidaridad, Kilómetros
de Salud” recorridos y vamos por muchos más.
Admifarm Group - Manteniendo lo esencial. |
|
|
|
PLANTA DE DENVER FARMA CUMPLIO
DOS AÑOS
 El
laboratorio nacional, Denver Farma, celebró durante noviembre,
el segundo aniversario de la inauguración de su planta de
producción en la localidad de Garín, provincia de Buenos Aires.
Este festejo está anclado a un dato de importancia. Es que
Denver pertenece al selecto grupo de laboratorios que
manufacturan insulina humana recombinante en todo el continente
de América latina. El
laboratorio nacional, Denver Farma, celebró durante noviembre,
el segundo aniversario de la inauguración de su planta de
producción en la localidad de Garín, provincia de Buenos Aires.
Este festejo está anclado a un dato de importancia. Es que
Denver pertenece al selecto grupo de laboratorios que
manufacturan insulina humana recombinante en todo el continente
de América latina.
Además del laboratorio argentino Denver Farma, hay una planta de
producción en México y otra en Brasil. Aunque de capitales
enteramente latinos sólo se encuentran las planta de Denver y la
ubicada en México, perteneciente al laboratorio Pisa.
La inversión destinada para montar esta planta requirió una
inversión de u$s 11 millones en la obra civil, además de u$s 5
millones adicionales destinados a adquirir tecnología
productiva. Este desembolso fue realizado con fondos propios de
la compañía y totalizó u$s 16 millones.
La planta, ubicada en el Centro Industrial Garín, partido de
Escobar, cuenta con más de 10.000 m2 de planta productiva y se
desempeñan allí más de 200 empleados.
La fábrica de Denver Farma posee áreas de producción de
comprimidos, líquidos y semisólidos (cremas), inyectables,
colirios y aerosoles. La planta incluye también un área de
control de calidad de última tecnología, depósitos y espacio de
oficinas.
Con una capacidad de producción de más de 30 millones de
unidades anuales (presentaciones en cajas, tanto individuales
como hospitalarias), la planta busca asistir tanto al mercado
interno como a los mercados externos. En la actualidad la
compañía está exportando a varios países de América latina.
 Esta
planta cumple con los estándares internacionales de calidad,
además de las “Buenas Prácticas de Manufactura” establecidas por
la Organización Mundial de la Salud. Esta
planta cumple con los estándares internacionales de calidad,
además de las “Buenas Prácticas de Manufactura” establecidas por
la Organización Mundial de la Salud.
Además, cabe destacar que se trata de una de las únicas tres
plantas nacionales que manufacturan aerosoles inhalatorios.
Fundada en 1989, Denver Farma se especializa además en la
producción de una extensa línea de medicamentos en las áreas de
Alergia, Antisepsia, Cardiología, Dermatología,
Gastroenterología, Infectología y medicamentos para
dolor/inflamación y las vías respiratorias, entre otras.
|
|
|

 MAPFRE
Y GALENO ALCANZARON UN ACUERDO ESTRATEGICO PARA LA
COMERCIALIZACION DE SUS PRODUCTOS EN LA ARGENTINA MAPFRE
Y GALENO ALCANZARON UN ACUERDO ESTRATEGICO PARA LA
COMERCIALIZACION DE SUS PRODUCTOS EN LA ARGENTINA
MAPFRE y GALENO han
alcanzado un acuerdo para el traspaso a la compañía argentina de
las actividades de Riesgos de Trabajo y Salud de MAPFRE en el
país. La operación contempla también la colaboración comercial
entre ambas entidades, por la cual las oficinas y agentes
exclusivos de MAPFRE en la Argentina continuarán distribuyendo
estos productos, y la red de GALENO comercializará productos
aseguradores de MAPFRE ARGENTINA.
Antonio Huertas, Presidente de MAPFRE, y Julio Fraomeni,
Presidente de GALENO, han firmado el acuerdo el 23 de octubre,
en la sede del Grupo MAPFRE en Madrid. Ambos han mostrado su
satisfacción por esta alianza, que mejorará el desarrollo de las
actividades de Riesgos de Trabajo y Salud en la Argentina.
“Con este acuerdo, ampliaremos la red de distribución de
nuestros productos aseguradores en el país”, afirmó Antonio
Huertas, “y además, nuestros clientes se beneficiarán de la
amplia experiencia de GALENO en la gestión de estos ramos y de
su excelencia en el servicio de Riesgos de Trabajo y Salud”. “La
colaboración con MAPFRE es positiva para nosotros desde todos
los puntos de vista”, añadió Julio Fraomeni, “ya que nos permite
continuar creciendo en un mercado en el que somos especialistas
y con el que estamos fuertemente comprometidos”.
A la firma del acuerdo asistieron también Rafael Casas,
Presidente de MAPFRE AMERICA; Diego Sobrini, Presidente de
MAPFRE en Argentina; José Manuel Vallejo, Director General de
MAPFRE AMERICA y Claudio Ramos, Director General de Asesoría
Jurídica de MAPFRE.
GALENO es un grupo empresarial argentino que desarrolla
actividades de seguro de Riesgos del Trabajo y de Salud. Cuenta
con la infraestructura de clínicas privadas más importantes del
país, que han recibido las máximas certificaciones de calidad.
En 2011 ingresó un total de 5.308,2 millones de pesos argentinos
(918 millones de euros) en estas actividades. Es la segunda
compañía en el ranking de Riesgos de Trabajo en la Argentina,
con 900.000 asegurados y una cuota de mercado del 10,4 por
ciento en ese sector. Además, cuenta con una cartera de 600.000
asegurados en planes de salud, mercado en el que es la tercera
entidad del país, con una cuota de mercado del 15 por ciento. |
|
|
LABORATORIO HIDALGO GANO EL 1° PREMIO DE CALILAB
 El
trabajo presentado por Laboratorio Hidalgo, “Evaluación del
desempeño de dos métodos para la medición de calcio en suero”,
fue galardonado con el primer premio de Calilab, “VII Congreso
Argentino de la Calidad en el Laboratorio Clínico V Jornada
Latinoamericana de la Calidad en el Laboratorio Clínico”. El
trabajo presentado por Laboratorio Hidalgo, “Evaluación del
desempeño de dos métodos para la medición de calcio en suero”,
fue galardonado con el primer premio de Calilab, “VII Congreso
Argentino de la Calidad en el Laboratorio Clínico V Jornada
Latinoamericana de la Calidad en el Laboratorio Clínico”.
El equipo autor del estudio está conformado por los bioquímicos
Guillermina Sand, Emilio Pesalovo, Mariángeles Puelles, Patricia
Bechi, Milva Sánchez, Gustavo Mokfalvi y Gustavo Maccallini.
Laboratorio Hidalgo presentó 10 posters, un número significativo
si se toma en cuenta que en total se presentaron aproximadamente
230 trabajos.
|
|
OSPAT TIENE SU ESPACIO DE RECOMENDACIONES SALUDABLES EN
TELEVISION
 Desde
el mes de agosto, la obra social OSPAT tiene su espacio
para la difusión de mensajes sobre hábitos saludables en
la Argentinos Pura Sangre TV, el programa de televisión
de la Unión de Trabajadores del Turf y Afines que se
emite por CN23 todos los sábados a las 10 de la mañana
con la conducción de Carlos Felice. Desde
el mes de agosto, la obra social OSPAT tiene su espacio
para la difusión de mensajes sobre hábitos saludables en
la Argentinos Pura Sangre TV, el programa de televisión
de la Unión de Trabajadores del Turf y Afines que se
emite por CN23 todos los sábados a las 10 de la mañana
con la conducción de Carlos Felice.
Desde este espacio televisivo auspiciado por OSPAT, la
nutricionista Viviana Langer brinda consejos simples y
fáciles de incorporar a la rutina cotidiana para tener
una alimentación saludable, ya que modificando algunos
hábitos alimenticios se logran prevenir numerosas
enfermedades y mejorar la calidad de vida de una manera
significativa.
Una alimentación equilibrada permite que el organismo
funcione adecuadamente, pero además, reduce el riesgo de
padecer ciertas enfermedades como hipertensión,
obesidad, diabetes, enfermedades cardiovasculares,
trastornos de la conducta alimentaria e, incluso,
ciertos tipos de cáncer. Es por ello que, OSPAT,
aprovecha un medio de comunicación masivo como la
televisión para llegar a nuevos públicos con mensajes
orientados a mejorar su salud.
Además de garantizar una asistencia médica de alta
calidad, la obra social de los trabajadores del turf se
involucra en el abordaje de las causas de aquellas
enfermedades que pueden prevenirse modificando hábitos
de vida y se consideran las verdaderas epidemias del
siglo XXI. Esto se logra con el esfuerzo de todos los
sectores sociales y, como dice el dicho popular, siempre
es “mejor prevenir que curar”
|
|
|
OMINT PROMOVERA EL TURISMO MEDICO EN ARGENTINA
 En
el marco de la ronda de negocios entre la Argentina y Brasil,
organizada por la Secretaría de Comercio Interior y encabezada
por el secretario de Comercio Interior -Guillermo Moreno- y de
la que participaron la secretaría de Comercio Exterior Beatriz
Paglieri y el cónsul Argentino Agustín Molina Arambarri, OMINT
celebró un acuerdo a través del cual el Grupo fortalecerá su
trabajo en la promoción del turismo médico en la Argentina. En
el marco de la ronda de negocios entre la Argentina y Brasil,
organizada por la Secretaría de Comercio Interior y encabezada
por el secretario de Comercio Interior -Guillermo Moreno- y de
la que participaron la secretaría de Comercio Exterior Beatriz
Paglieri y el cónsul Argentino Agustín Molina Arambarri, OMINT
celebró un acuerdo a través del cual el Grupo fortalecerá su
trabajo en la promoción del turismo médico en la Argentina.
De esta forma, pacientes provenientes de Brasil y del resto de
Latinoamérica podrán acceder a atención médica de alta calidad,
internacionalmente reconocida y a valores competitivos en
cirugías y tratamientos para patologías especialmente complejas,
cirugías estéticas y prestaciones odontológicas en la República
Argentina.
Esta modalidad que conjuga la posibilidad de tratamientos
médicos y turismo, es una cualidad que crece en la Argentina
debido al reconocido nivel médico de sus profesionales e
instituciones; el turismo médico representa una oportunidad para
que los pacientes viajen para obtener atención médica de primer
nivel a menores costos y tiempos de espera para el acceso a la
atención, también menores. El acuerdo fue suscripto durante el
encuentro celebrado el 8 de noviembre en la Federación de
Industrias del Estado de São Paulo y del cual participaron
autoridades gubernamentales argentinas, brasileñas y los
principales ejecutivos de OMINT argentina y Brasil.
|
| |
|
|
Siguiente >> |
|
|
|
|